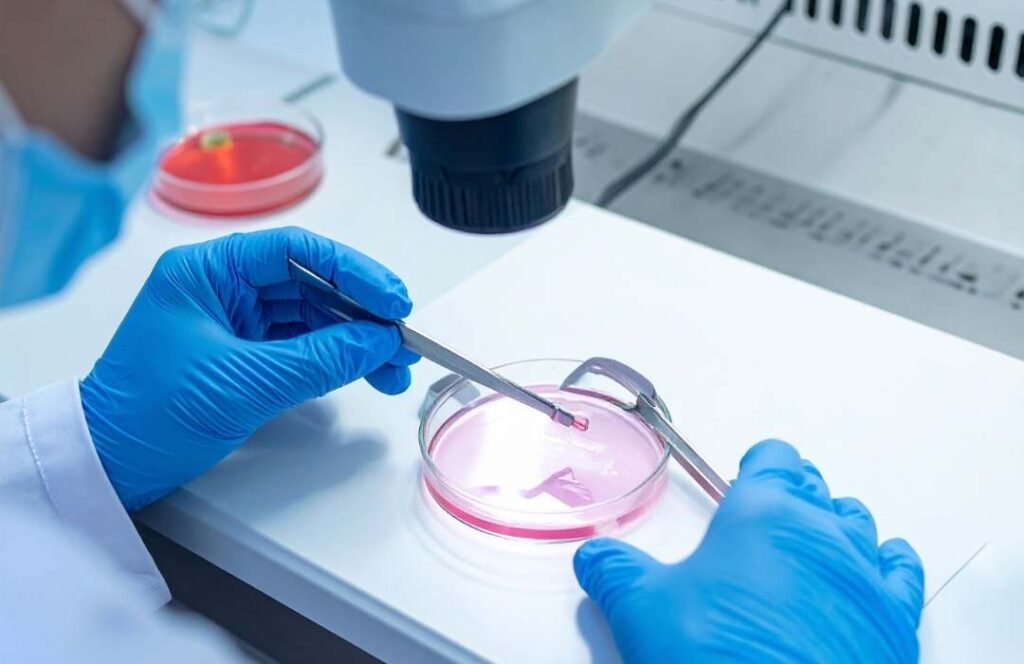

Dr. Gazal Garg
Hi, I Am Dr. Gazal Garg
Consultant - Obstetrics and Gynaecology, Cloud 9 hospital, Dwarka
Dr. Gazal Garg is a highly experienced Obstetrician & Gynaecologist in Dwarka, New Delhi, with over a decade of expertise in women’s healthcare. She specializes in high-risk pregnancy management, infertility treatments (IUI/IVF), prenatal and postnatal care, menstrual and hormonal disorders, and advanced gynecological surgeries. Trained in Infertility Management (IIRM, Kolkata), Ultrasonography in Obstetrics & Gynaecology (Mumbai), and vaginal hysterectomy (Purohit General Hospital, Odisha), Dr. Garg combines modern medical techniques with compassionate care. She has served at renowned institutions including DDU Hospital, Rockland Hospital, Manipal Hospital, and Aakash Hospital, and is currently associated with Cloud 9 Hospital. Known for her patient-centric approach, she is committed to providing safe, effective, and personalized care for women at every stage of life.
- 2010-13- M.S (OBGY) from D.Y. Patil Hospital and Research Centre. Pune
- 2003-09- M.B.B.S from Bharati Vidyapeeth Medical College, Pune
- 2003- H.S.C from Kendriya Vidyalaya, Vikaspuri
New Delhi - 2001- S.S.C from- Kendriya Vidyalaya, Vikaspuri
New Delhi
- Associate consultant in Department of Obstetrics and Gynaecology, Aakash Healthcare super specialty Hospital from October 2020 To September 2021
- Specialist in Department of Obstetrics and Gynaecology, Manipal Hospital (HCMCT), Dwarka, New Delhi since October 2018 to October 2020
- Attending consultant, Obstetrics and Gynaecology, Rockland hospital, Dwarka , New Delhi.
- Senior Resident For 3 years in Department of OBGY at Deen Dayal Upadhyay hospital (Govt. of NCT of Delhi), Hari Nagar, New Delhi, from 18th January 2014 to 17th January 2017.
- Senior Resident of OBGY at Guru Gobind Singh Gov. Hospital (Govt. of NCT of Delhi), Raghubir Nagar, New Delhi from 7th November 2013 to 17th January 2014.
- PUBLICATION: CASE REPORT: Septate Uterus with complete cervical and vaginal duplication –a Rare Mullerian Malformation.
- Paper Presentation at International Annual Conference of the Indian Association of Gynaecological Endosopists, 2011.
- Poster Presentation at – AMOGS 2012, Nanded, Maharashtra.
- Orientation workshop on Comprehensive Abortion Care, BVDUMC 2009, Pune.
- Sankalp 2010, CME on Critical Care, BVDUMC 2010, Pune.
- Workshop on Hysteroscopic Surgery Ashwini Hospital and Endoscopy Centre, Pune 2010.
- AMOGS Conference Jan 2012, Nanded Obstetric and Gynaecological Society.
- Endosurg 2010, Pune – Horizons of Minimal Access Surgery.
- Workshop on Hysteroscopy Surgery in D.Y. Patil Medical College, Pune 2012.
- 52 weeks Rotating Internship in all Departments at Bharati Hospital, Pune.
- 31 months in the Department of OBGY, D.Y Patil Medical College and Hospital, Pune.
- Three years experience as Senior Resident in Department of Obstetrics and Gynaecology at Deen Dayal Upadhayay Hospital. New Delhi (Govt. of NCT of Delhi)
- Teaching of Undergraduate Students during 2nd & 3rd year of Residency.
- Teaching of DNB students during senior residency at DDU hospital, Hari Nagar,
14+
Years Experience
300+
Pregnancy Done
8000+
Happy Patients
Services Provided by Dr. Gazal Garg

Book Your Appointment
Take the first step towards better health and wellness
